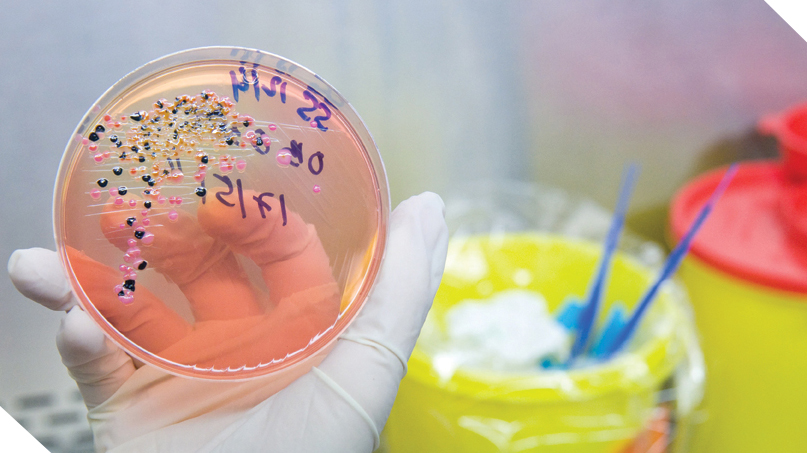
Donor Report

Your Contributions to CDC's Life-Saving Work
![]() |
|
In Fiscal Year 2011, the CDC Foundation helped CDC make real progress in fighting global disease and death from tobacco use, malaria, pneumococcal disease, viral hepatitis, and the health consequences of large-scale disasters. |
With Gratitude
The CDC Foundation gratefully acknowledges the generous support of foundations, corporations, organizations and individuals. This support, totaling $49 million in the fiscal year beginning July 1, 2010 and ending June 30, 2011, enables the CDC Foundation to help CDC do more, faster, to keep America healthy, safe and secure.
Tax-deductible contributions are used to support the areas of greatest need in our work on behalf of CDC or may be designated for specific purposes. For more information about gift opportunities please contact the Advancement Department at 404.653.0790 or 888.880.4CDC or visit cdcfoundation.org/givenow. Thank you for your continued loyalty.
Looking Back
Gary Cohen, CDC Foundation Board Chair |
Looking Forward
Charlie Stokes, CDC Foundation President and CEO |
Back to Donor Report Home | Next Page: Message from the Chair of the Board of Directors